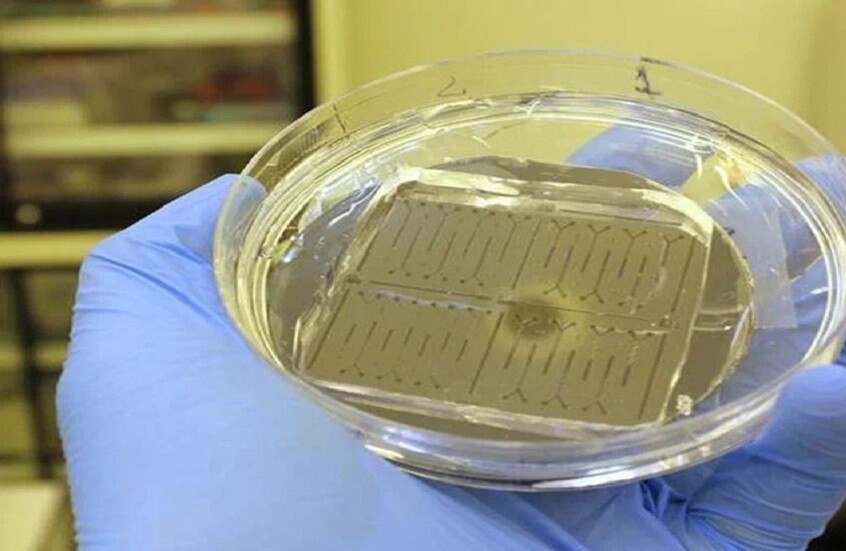

كتب : دينا كمال
جهاز روسي يرصد مؤشرات الشيخوخة والأمراض بدقة أعلى
طوّر باحثون في جامعة آي تي إم أو جهاز استشعار متقدما يعتمد على قنوات ميكروية دقيقة، قادر على رصد أنواع الأكسجين التفاعلية التي يؤدي ارتفاعها إلى حدوث إجهاد تأكسدي داخل الجسم.
أوضحت دراسة نشرتها Microchemical Journal أن الإجهاد التأكسدي يساهم في تسريع مظاهر الشيخوخة ويرفع احتمالات الإصابة بأمراض القلب والأوعية الدموية واضطرابات الدماغ.
تتراكم أنواع الأكسجين التفاعلية في جسم الإنسان نتيجة عوامل متعددة، من بينها تلوث الهواء والتدخين والأمراض المزمنة. ويتسبب تجاوزها المستويات الطبيعية في إلحاق أضرار بالبروتينات والحمض النووي، ما يؤدي إلى اضطراب التوازن الخلوي. وتعتمد طرق القياس التقليدية على رصد التألق الضوئي أو الكيميائي، إضافة إلى إدخال كواشف يدويا، وهو ما قد يطيل زمن الاختبار ويؤثر في دقته.
ابتكر الفريق البحثي شريحة ميكروفلويدية صغيرة يمر عبرها اللومينول، وهو مركب كيميائي صيغته (C8H7N3O2) معروف بقدرته على إصدار ضوء كيميائي، إلى جانب محلول يحتوي على أنواع الأكسجين التفاعلية. وتعمل القنوات الدقيقة المصممة ببنية خاصة على خلط السوائل بسرعة عالية، قبل انتقالها إلى منطقة قياس التألق، حيث يحدث التفاعل في جزء من الثانية.
أكد العلماء أن الجهاز الجديد يتيح قياس مستويات أنواع الأكسجين التفاعلية بدقة تزيد بمقدار يتراوح بين 1.5 و2 مرة مقارنة بالأساليب التقليدية، فضلا عن تمكين الباحثين من متابعة آليات التفاعل في الزمن الحقيقي، ما يعزز فرص التشخيص المبكر وفهم العمليات البيوكيميائية المرتبطة بالأمراض.